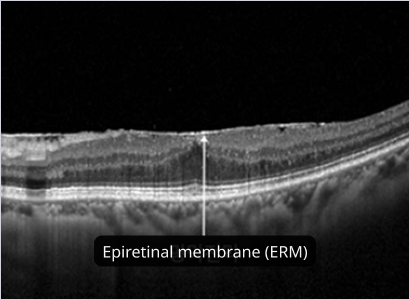

-
Sign Up
- |
-
Find ID / Password
-
-
Social Login
-
Your ID is .
Password Changed
Your password has been changed.
Please log in with your new password.